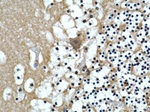
COPG2 Antibody in Immunohistochemistry (Paraffin) (IHC (P))

Search
Proteintech
COPG2 Polyclonal Antibody
{{$productOrderCtrl.translations['antibody.pdp.commerceCard.promotion.promotions']}}
{{$productOrderCtrl.translations['antibody.pdp.commerceCard.promotion.viewpromo']}}
{{$productOrderCtrl.translations['antibody.pdp.commerceCard.promotion.promocode']}}: {{promo.promoCode}} {{promo.promoTitle}} {{promo.promoDescription}}. {{$productOrderCtrl.translations['antibody.pdp.commerceCard.promotion.learnmore']}}
产品信息
16111-1-AP
种属反应
已发表种属
宿主/亚型
分类
类型
抗原
偶联物
形式
浓度
规格
纯化类型
保存液
内含物
保存条件
运输条件
产品详细信息
Immunogen sequence: EVRDRATFY LNVLQQRQMA LNATYIFNGL TVSVPGMEKA LHQYTLEPSE KPFDMKSIPL AMAPVFEQKA EITLVATKPE KLAPSRQDIF QEQLAAIPEF LNIGPLFKSS EPVQLTEAET EYFVRCIKHM FTNHIVFQFD CTNTLNDQLL EKVTVQMEPS DSYEVLSCIP APSLPYNQPG ICYTLVRLPD DDPTAVAGSF SCTMKFTVRD CDPNTGVPDE DGYDDEYVLE DLEVTVSDHI QKVLKPNFAA AWEEVGDTFE KEETFALSST KTLEEAVNNI ITFLGMQPCE RSDKVPENKN SHSLYLAGIF RGGYDLLVRS RLALADGVTM QVTVRSKERT PVDVILASVG (517-865 aa encoded by BC017443)
靶标信息
The coatomer is a cytosolic protein complex that binds to dilysine motifs and reversibly associates with Golgi non-clathrin-coated vesicles, which further mediate biosynthetic protein transport from the ER, via the Golgi up to the trans Golgi network.
仅用于科研。不用于诊断过程。未经明确授权不得转售。
生物信息学
蛋白别名: coat protein, nonclathrin, gamma-2-cop; coatomer protein complex subunit gamma 2; Coatomer subunit gamma-2; FLJ11781; Gamma-2-coat protein; Gamma-2-COP; gamma-COP homolog; testicular secretory protein Li 12; unnamed protein product
基因别名: 2-COP; AW227625; COPG2; gamma-2-COP
UniProt ID: (Human) Q9UBF2, (Mouse) Q9QXK3
Entrez Gene ID: (Human) 26958, (Mouse) 54160